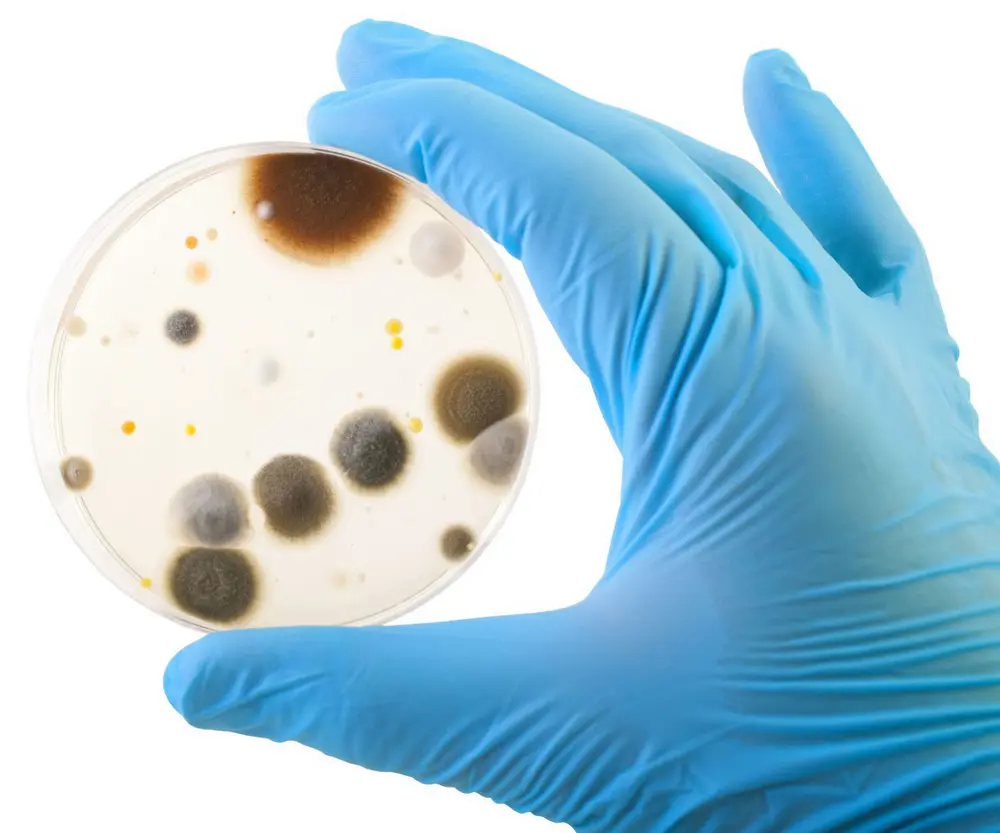
L’abaissement de la pression d’infection et l’optimisation du processus de désinfection est une étape à ne pas sous-estimer et extrêmement cruciale vers une transformation des aliments sécurisante

La desinfection automatique abaisse la pression bacterienne
Prevention de l'infection dans l'alimentation
Les producteurs alimentaires doivent constamment faire un compromis entre production maximale et nettoyage maximal. Quels que soient les produits qui sortent des chaînes dans votre entreprise, le risque de contamination ou de contamination croisée par des infections n’est jamais totalement exclu. Les moisissures, bactéries, virus et levures méritent une attention suffisante dans l’élaboration et la mise en œuvre de plans d’hygiène. Tout comme le CIP se charge d’un nettoyage automatisé, contrôlé et attesté de vos canalisations et citernes, la nébulisation peut désinfecter votre aire de production de façon efficace.
L’IMPORTANCE DE LA DESINFECTION DE SURFACE EFFICACE
Ils ne sont pas ou à peine visibles à l’œil nu mais pourtant les bactéries, levures, moisissures et virus sont toujours à l’affût dans un environnement de transformations alimentaires. Cela demande une approche approfondie
des risques dans votre production car la santé du consommateur doit primer pour toute entreprise alimentaire.
Saviez-vous aussi que l’investissement est réellement payant? Vous êtes-vous en effet demandé ce que vous coûterait un dysfonctionnement et un rappel obligatoire de vos produits? Si la valeur de production perdue figure sur l’addition, il en va de même pour la perte d’image encourue. Et cela sera peut-être encore le plus difficile à faire oublier.
FACTEURS QUI FAVORISENT LA CONTAMINATION
Dans un environnement de transformations alimentaires, le risque de contamination par, par exemple, la listeria, la salmonelle ou l’E. Coli ne peut jamais être totalement exclu. En raison des tendances actuelles dans le comportement du consommateur, le risque est de surcroît encore plus grand.
Un exemple en sont les habitudes alimentaires que nous avons recensées aux quatre coins du monde. Si le sushi et le carpaccio rencontrent le succès auprès du consommateur, la transformation des produits de viande et de poisson
crus comporte des risques supplémentaires. Idem pour le marché croissant des plats cuisinés et des légumes et fruits prédécoupés. Ceux-ci demandent une consommation immédiate et dès lors des techniques de conservation plus douces, ce qui favorise bien entendu le risque d’infection des consommateurs. Du reste, les techniques de conservation ‘dures’, populaires, du passé – saumurage, fumage ou séchage – perdent du terrain aujourd’hui. Néanmoins elles allongent la durée de conservation et limitent le risque d’organismes pathogènes ou de pourriture.
En outre, les collaborateurs peuvent diffuser des germes pathogènes dans votre processus de production. Ceci fait que les environnements de production peuvent se transformer de high-care (minimiser le risque de contamination) à high-risk (traitement préventif des risques de contaminations).
LE DANGER DES BIOFILMS

L’exemple par excellence d’une pollution qui peut donner lieu à un foyer d’infections dans l’industrie alimentaire concerne les biofilms. Ils apparaissent
quand un groupe de micro-organismes s’agglutine sur une surface. Ils sont collants, tenaces et dès lors difficiles à enlever, et ils ne sont pas
toujours visibles à l’œil nu.
Un biofilm comprend des bactéries vivantes auxquelles la désinfection ne peut pas remédier. Mais il existe des solutions spécifiques pour les détecter et les enlever, ce qui aide à rendre la désinfection 100% efficace. Une présence accrue de biofilms augmente le risque de contamination microbienne des aliments. Dans des cas extrêmes, ceci peut conduire à des foyers de listeria, salmonelle et moisissures.
L’abaissement de la pression d’infection et l’optimisation du processus de désinfection est une étape à ne pas sous-estimer et extrêmement
cruciale vers une transformation des aliments sécurisante.
APPROCHE MANUELLE OU AUTOMATIQUE
Il est donc recommandé d’accorder une attention suffisante à la prévention des contaminations possibles dans vos plans d’hygiène. Le législateur et les chaînes retail en sont aussi demandeurs et porteront un regard de plus en plus sévère sur l’hygiène dans les usines alimentaires. L’approche de la désinfection peut du reste s’opérer de différentes manières:
manuelle ou automatique, ou une combinaison des deux.
Quelle que soit l’option choisie, il faut toujours partir du principe que vous devez d’abord vous attaquer à la source de la pollution au moyen d’un nettoyage en profondeur. A défaut, les problèmes seront récurrents. La désinfection ne démontrera réellement son utilité pour maintenir au plus bas la pression bactérienne dans votre production que quand la pollution est éliminée.
DESINFECTION MANUELLE
Traditionnellement, la désinfection est assurée manuellement par l’équipe d’entretien qui se charge aussi du nettoyage de vos aires et machines de production. Après le nettoyage, on applique une mousse, un spray … ayant une action désinfectante.

Il existe toutes sortes de produits de nettoyage qui visent spécifiquement un seul groupe de dangers ou des ‘allrounders’ qui luttent en même temps contre les bactéries, les moisissures, les levures et les virus. L’important est de toujours rincer, de manière à ne pas laisser de résidus ou de choisir un produit à faible valeur MRL (maximum residue level) qui ne laisse aucun résidu ou des résidus pour lesquels il n’existe pas de MRL. Le post-rinçage mérite certainement une attention suffisante pour éviter que des résidus de produit entrent en contact avec l’alimentation.
Avantages et désavantages
La limite de la méthode de travail manuelle est que certaines surfaces restent intactes et ne seront donc pas désinfectées. Songez par exemple aux hauts plafonds ou aux systèmes de traitement de l’air. Le grand avantage est la flexibilité. Si une certaine ligne donne lieu à un risque accru, ceci peut être facilement indiqué et traité.
DESINFECTION AUTOMATIQUE
Les entreprises alimentaires peuvent opter de surcroît pour une approche automatique au moyen de la nébulisation à l’aide d’appareils de pulvérisation. Cette technique spécifique a déjà largement fait ses preuves dans le secteur des soins mais peut également présenter de très beaux résultats en ce qui concerne l’industrie alimentaire.
Avantages et désavantages
Dans la nébulisation, les désinfectants sont pulvérisés en petites gouttes à travers l’aire de production, avec le grand avantage de traiter également les endroits nettement plus difficiles d’accès.
La nébulisation classique connaît une action mouillée, Cela veut dire que l’on répand le désinfectant dans l’espace de telle sorte que l’air complet en est saturé. La conséquence est que des précipitations se manifestent sur toutes les surfaces et garantissent une action désinfectante. Ici aussi la règle veut qu’un post-rinçage approfondi est tout indiqué pour s’assurer que les aliments ne peuvent pas entrer en contact avec le résidu.
Ou on peut bien entendu opter pour des produits ayant une valeur MRL favorable. L’exigence éventuelle d’un post-rinçage sera enregistrée sur l’autorisation. Pour pouvoir servir pour la nébulisation, le produit en question doit impérativement disposer de toutes les bonnes revendications.
L’inconvénient de ce traitement est qu’il réclame le temps nécessaire.
Innovations dans la nébulisation

La technique ne s’arrête toutefois pas. A l’heure actuelle, il existe déjà des pulvérisateurs sur le marché qui garantissent une action sèche.
Par un apport de chaleur pendant la pulvérisation, les gouttes sont ionisées. L’ionisation renforcera la force d’attraction entre les particules chargées positivement du composant actif (désinfectant) d’une part et les surfaces à désinfecter chargées négativement d’autre part. Les gouttes doivent aussi être suffisamment petites pour créer un brouillard sec, au lieu de saturer l’air. Le pulvérisateur est conçu de telle sorte que le
désinfectant doit passer à travers des conduits venturi. Le vide aspire le produit, ce qui le projette en gouttes de 5 µm. Après ce processus, celles-ci sont envoyées dans l’aire de production à une très grande vitesse, ce qui leur permet d’atteindre leur but indépendamment des flux d’air présents.
Reproductible et contrôlable
L’une des principales raisons de passer à la désinfection automatique est la reproductibilité et le caractère contrôlable du processus de désinfection. La désinfection se produira à chaque fois exactement de la façon prescrite. Grâce à cette grande répétabilité, l’application peut être mieux validée. La validation n’est pas seulement un instantané mais de surcroît une référence pour tous les autres jours. On peut de cette façon montrer aux autorités que tout s’est certainement déroulé dans les règles de l’art. Tout est parfaitement mesurable de cette manière.
Préparation de la nébulisation
Afin de pouvoir profiter de ces avantages mentionnés, la nébulisation doit bel et bien être précédée d’une préparation très approfondie.
La mise en œuvre d’une désinfection efficace débute par l’identification des endroits faibles dans une aire de production. Le rouleau à l’extrémité du convoyeur à bande en est un exemple classique mais cela vaut pour chaque endroit dans la zone de production qui n’est pas atteint par l’air et dès lors aussi par le désinfectant. Du reste, ce sont également souvent les zones qui méritent une attention particulière. Leur identification préalable permet de trouver une solution adéquate: par exemple l’ouverture du convoyeur à bande pour la désinfection ou la finition manuelle de cette zone. Ce sont également les zones qu‘on peut le mieux contrôler la suite, pour être certain du résultat.
Dans la phase suivante suit une validation sur place. Demandez à votre fournisseur de montrer l’efficacité de la désinfection dans votre propre aire de production. En fonction de la surface et de la disposition de certaines machines, on doit en effet bien dimensionner les appareils (fixes ou mobiles). Par ailleurs, la fréquence jouera son rôle et devra être déterminée à l’avance.
Avec la collaboration de CID Lines, Medtradex en Realco